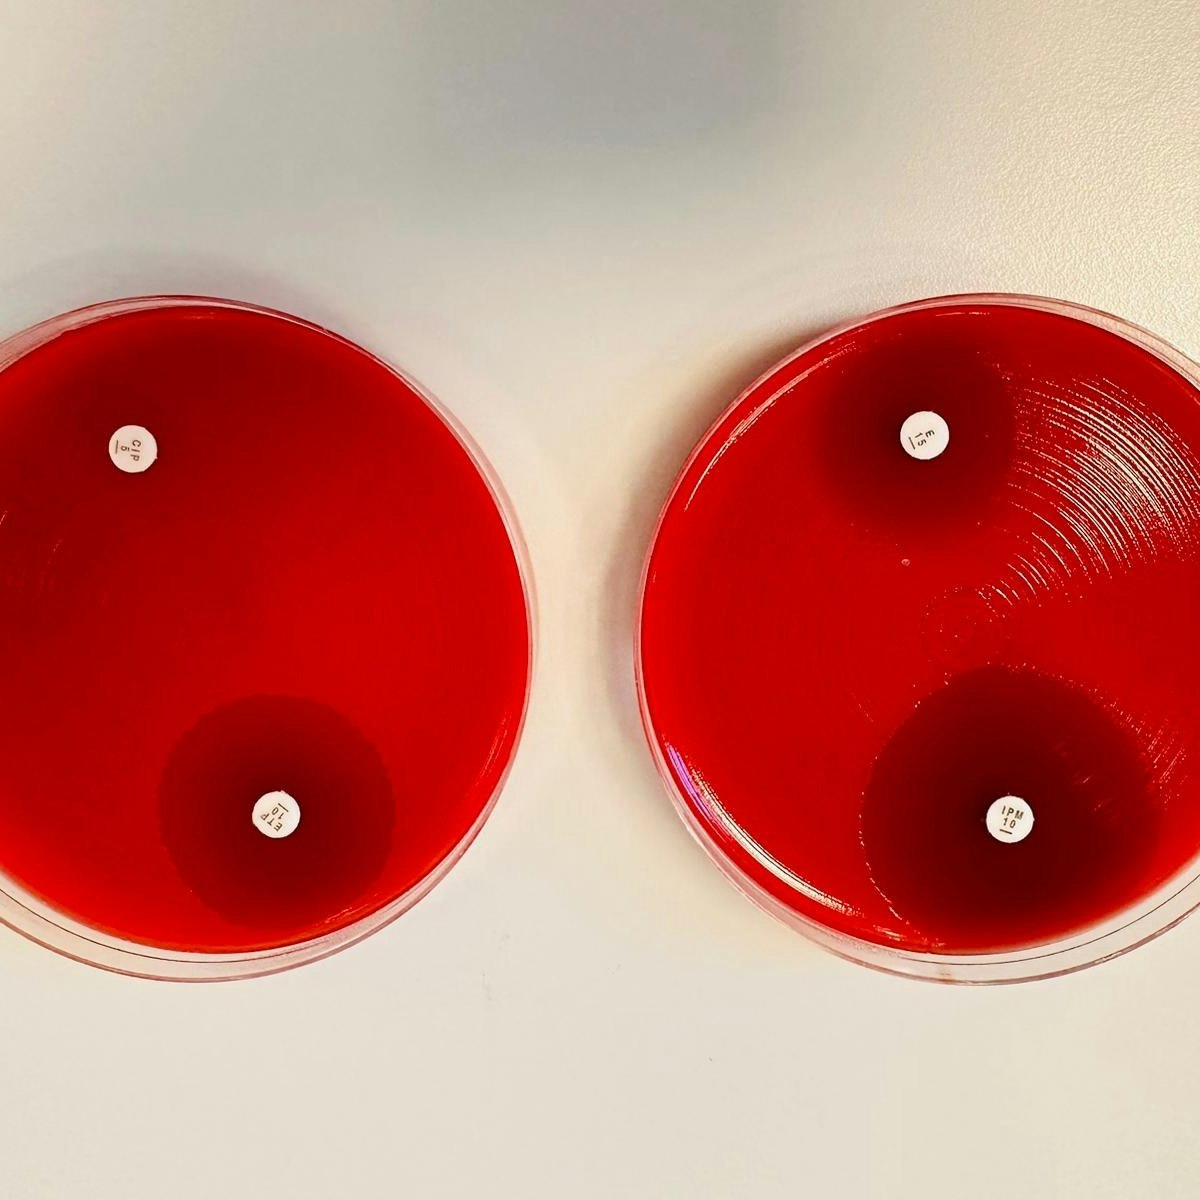

Drug discovery courses can help you learn the drug development process, target identification, lead optimization, and clinical trial design. You can build skills in molecular modeling, high-throughput screening, and data analysis techniques. Many courses introduce tools like cheminformatics software, bioinformatics platforms, and laboratory techniques that are crucial for analyzing compounds and assessing their effectiveness.
Technical University of Denmark (DTU)
Skills you'll gain: Laboratory Testing, Quality Assurance, Microbiology, Infectious Diseases, Bioinformatics, Medical Laboratory, Molecular, Cellular, and Microbiology, Epidemiology, Public Health and Disease Prevention, Data Quality, Medical Science and Research, Biology, Public Health
Intermediate · Course · 1 - 3 Months

The Pennsylvania State University
Skills you'll gain: Infectious Diseases, Epidemiology, Public Health and Disease Prevention, Microbiology, Public Health, Pathology, Immunology, Preventative Care, Sanitation, Social Determinants Of Health, Social Sciences, Community Health, Molecular, Cellular, and Microbiology, Medical Science and Research, Biology, Drug Development, Social Network Analysis, Case Studies
Mixed · Course · 1 - 3 Months

Skills you'll gain: Clinical Trials, Drug Development, Patient Evaluation, Pharmaceutical Terminology, Clinical Assessment, Quantitative Research, Data Literacy, Patient-centered Care, Statistical Methods, Data Science, Statistical Analysis
Intermediate · Course · 1 - 4 Weeks

Universitat Politècnica de València
Skills you'll gain: Cybersecurity, Cyber Attacks, Computer Security Awareness Training, Distributed Denial-Of-Service (DDoS) Attacks, Encryption, Security Awareness, Data Security, Personally Identifiable Information, Email Security, Cyber Risk, Malware Protection, General Data Protection Regulation (GDPR), Information Privacy, Multi-Factor Authentication, Identity and Access Management
Beginner · Course · 1 - 4 Weeks

Skills you'll gain: SQL, Peer Review, Jupyter, Data Literacy, Data Mining, Data Modeling, Data Collection, Business Analysis, Relational Databases, Stored Procedure, Databases, Data Science, Big Data, Computer Programming Tools, Query Languages, Data Visualization Software, Decision Tree Learning, Predictive Modeling, Cloud Computing, Python Programming
Build toward a degree
Beginner · Specialization · 3 - 6 Months

University of California, Davis
Skills you'll gain: Intellectual Property, Research, Research Methodologies, Personal Development, Research Design, Research and Design, Curiosity, Science and Research, Problem Solving, Persistence, Persuasive Communication, Time Management, Student Engagement, Goal Setting, Journals, Communication, Ethical Standards And Conduct, Strategic Thinking, Decision Making, Safety and Security
Beginner · Specialization · 3 - 6 Months

Skills you'll gain: Design Thinking, Customer experience strategy (CX), Agile Product Development, Product Strategy, Product Management, User Research, Service Design, Value Propositions, Product Roadmaps, Customer Insights, User Story, Innovation, Market Opportunities, Customer Retention, Growth Strategies, Market Analysis
Intermediate · Course · 1 - 3 Months

Skills you'll gain: Prompt Engineering, Responsible AI, Prompt Patterns, ChatGPT, Generative AI, Digital Advertising, Email Marketing, Digital Marketing, Search Engine Optimization, Marketing Automation, AI Personalization, Advertising Campaigns, Marketing, Marketing Strategies, Content Creation, Web Analytics and SEO, AI Product Strategy, Keyword Research, Social Media Marketing, Artificial Intelligence and Machine Learning (AI/ML)
Beginner · Specialization · 3 - 6 Months

Skills you'll gain: Google Cloud Platform, YAML, Restful API, Load Balancing, Configuration Management
Intermediate · Course · 1 - 4 Weeks

Skills you'll gain: Empowerment, Coaching, Personal Development, Optimism, Accountability, Journals, Positivity, Mentorship, Lifelong Learning, Self-Awareness, Empathy, Resilience, Goal Setting, Relationship Building, Creativity
Beginner · Course · 1 - 3 Months

Skills you'll gain: Content Performance Analysis, Generative AI, Earned Media, Web Content, Prompt Engineering, Keyword Research, AI Personalization, Search Engine Optimization, Shared Media, Content Creation, Content Strategy, Content Marketing, Public Relations, Owned Media, ChatGPT, Copywriting, No-Code Development
Beginner · Course · 1 - 3 Months

Skills you'll gain: Google Gemini, Generative AI, Prompt Engineering, ChatGPT, Search Engine Optimization, Data Ethics, Performance Measurement, Web Analytics and SEO, Content Creation, AI Personalization, Lead Generation, Metadata Management, Content Strategy, Information Architecture
Beginner · Course · 1 - 3 Months